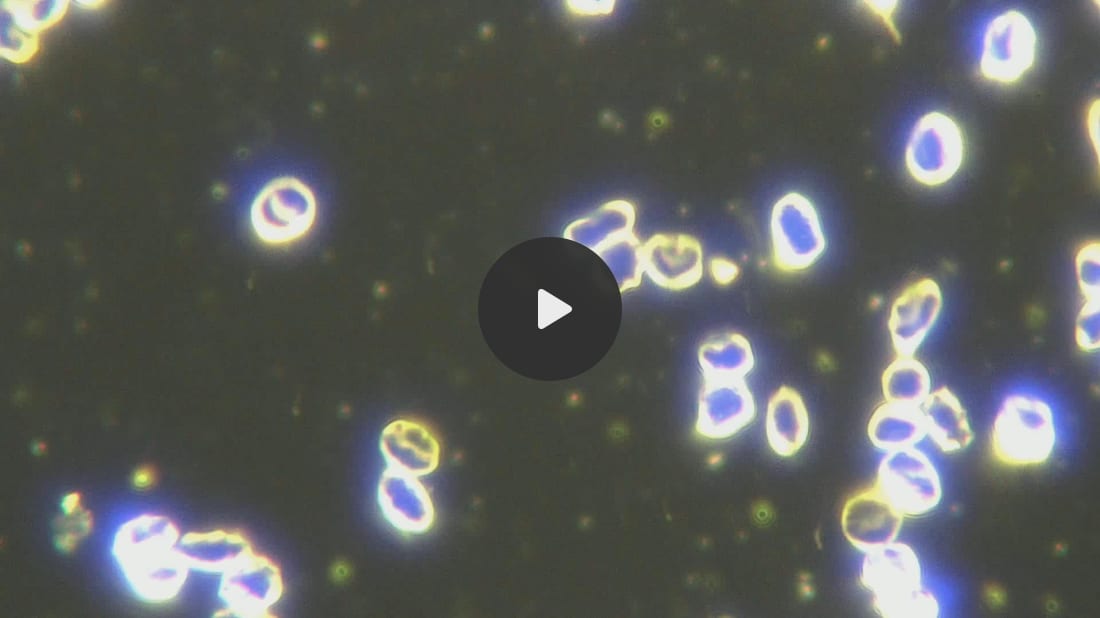

COVID19 Embalmed Blood For Over 2 Years Shows Continued Self Assembly Nanotechnology Replication, Nano and Microrobot Activity
Wed 2:35 am +00:00, 4 Sep 2024| Image: Embalmed Blood and spherical micellar construction sites filled with nanorobots In May/June 2023 Embalmer Richard Hirschman, sent me embalmed blood of a COVID19 vaccinated individual who had died with the rubbery clots. I had wanted to analyze the coffee grounds that he had been seeing in the embalming process. By the time I received the blood, the individual had been dead for more than 8 months. My analysis of the blood showed self assembly nanotechnology. I did an interview with Maria Zeee in June of 2023 about this. Please see the presentation here: My Interview With Maria Zeee – Biden’s Universal Nanotechnology Vaccine & “Zombie” Blood I had kept the vial in the refrigerator and wanted to know if there was any decrease in activity. Unfortunately, there was not, and I filmed immense nano and microrobot activity and continued self replication. In this video you can see how a new micelle filled with nanorobots is being expelled You can see how the polymer nanobots are moving quite fast to assemble themselves. Magnification 2000x Here you can see clearly that the nanorobots are moving, just like in the live blood as I have been showing in other posts. Oil Objective Magnification 4000x Here you can see a microrobot on its path through the embalmed blood. Magnification 2000x Here you can see many nano and microrobots swimming in the embalmed blood. Magnification 2000x The same polymer filaments we see in live blood are also in the embalmed blood. Magnification 400x. The same construction zones and polymer agglomerations also seen Summary: The COVID19 bioweapons are the most evil satanic crime against humanity ever perpetrated. We know that gravesites continue to show MAC address emission from the deceased COVID19 injected individuals. The nano and microrobots do not die, they continue their activity after death and continue self assembly. The Satanists have succeeded in creating the living undead – Zombies. |